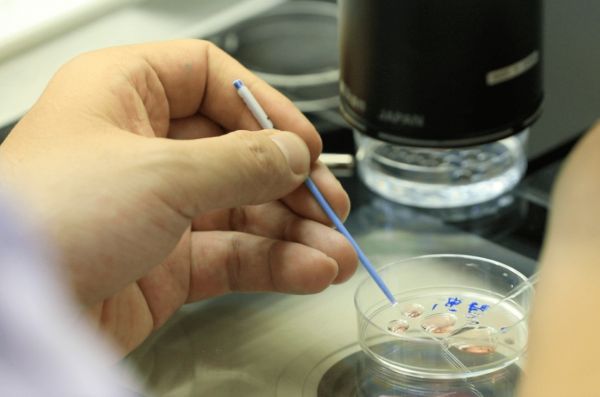

原标题:用冻卵徐静蕾怀孕了?有指征的女性,建议35岁之前做这件事
用冻卵徐静蕾怀孕了?有指征的女性,建议35岁之前做这件事
文/羊城晚报全媒体记者 张华
通讯员 张璟 张瑜婷 蔡佳琪
图/医院提供
近日,有媒体发布消息称,国家卫健委有关部门就“放开单身女性冻卵”征求专家意见,虽然这一消息仍有待官方确认,但随即登上热搜,受到女性普遍关注。记者了解到,最近很多年轻女性打电话到广东省生殖医院咨询卵子冷冻相关事宜。

广东省生殖医院生殖医学中心胚胎实验室
冻卵让她有“后悔”机会
作为娱乐圈里的“冻卵尝试者”,早在2013年徐静蕾为自己留下了以后做母亲的机会,在美国加州冷冻了9颗卵子,并公开谈论自己的冻卵经历。最近有媒体报道,今年48岁的徐静蕾可能怀孕了。如果消息确切,这再一次说明冻卵的重要性。
“冻卵”是一项什么技术呢?广东省生殖医院生殖中心主任宋革教授介绍,正常女性在一个月经周期仅能排出一枚成熟卵子。有冻卵需求的女性需要进行药物促排卵,让更多的卵子长大并成熟。卵子成熟后,医生会进行取卵手术。卵子取出后,实验室工作人员会将卵子周围的颗粒细胞脱去,在冷冻液保护下,放入-196度的液氮下超低温冷冻保存。此后,卵子就处于“冬眠”状态。

冻卵的流程
冻卵只适用于两类人群
宋革教授指出,根据我国目前的法律法规,医疗机构只能给婚姻关系内的夫妇进行辅助生殖。“冻卵主要应用于两类人群:一是需要进行放疗或化疗的肿瘤患者,因为一些治疗可能对生育力造成不可逆的破坏,所以她们需要在治疗前进行生育力保存;二是进行体外授精辅助生殖治疗时,因取卵当日男方取精失败或出现生殖道感染时,女方则可以进行卵子冷冻。目前在我们生殖中心冻卵的,以因肿瘤等原因需要保存生育力的人群为主”,宋革教授说。
冻卵的流程
35岁前冻卵有五成机会“抱宝宝”
“冻卵”如何实现生育呢?还需要一个过程,比如卵子复苏、精卵结合、受精卵移植,再到妊娠。
宋革教授称,目前采用卵子玻璃化冷冻技术,卵子复苏存活率在80%-95%。因为卵子是人体最大的细胞,体积较大,且含有大量水分,在冷冻过程中容易形成细胞内冰晶,进而损伤卵子,因此冷冻卵子对冷冻技术要求非常苛刻。

冻卵的流程
宋革教授还指出,25-35岁是生育的最好时机,也是卵子质量最佳的时期,因此有指征的女性建议在35岁之前冻卵。“目前的研究表明,35岁以下的卵子冷冻女性累计活产率为50%,是35岁以上人群的2倍以上(22.9%)。”
Tips:
在我国,冻卵尚未对健康的未婚女性开放。暂时没有生育打算,又担心年龄增长影响生育的育龄期女性朋友,可以先来生殖中心进行生育力评估,医生会根据每个人的卵巢功能情况进行具体的生育指导。
责任编辑:


还没有内容